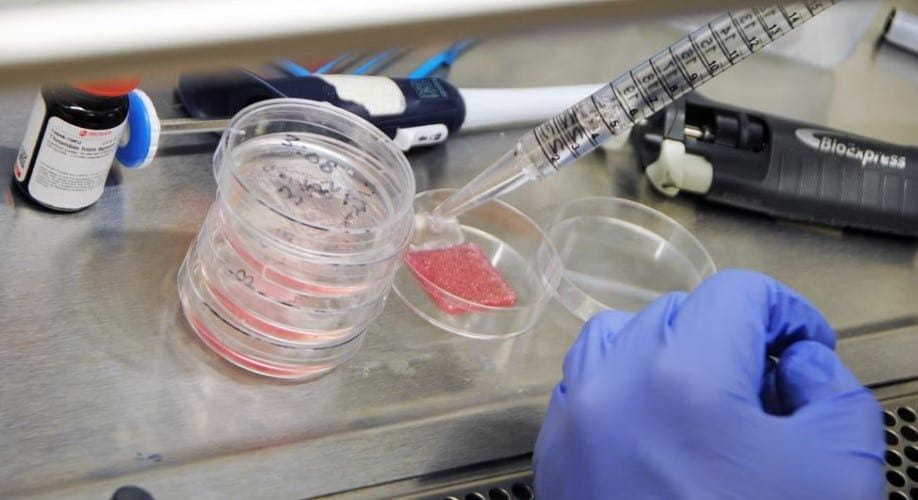
scars

Bioprinted skin may revolutionize wound healing, offering full-thickness regeneration and reducing scarring. Explore implications for your practice.
People recovering from wounds or severe burns might one day be treated with fully functional “bioprinted” skin created in a lab, a new study suggests.
Researchers say they “printed” skin samples containing all six major human cell types found in skin.
The result was multi-layered, full-thickness skin containing all three layers present in normal human tissue: epidermis, dermis and hypodermis.
Test transplants performed in the lab found that the bioprinted skin formed blood vessels and skin patterns, essentially functioning and forming as normal human tissue.
Other tests demonstrated improved wound closure, reduced skin contraction, and more collagen production to reduce scarring, the researchers reported.
The report was published Oct. 4 in the journal Science Translational Medicine.
“Comprehensive skin healing is a significant clinical challenge, affecting millions of individuals worldwide, with limited options,” said lead researcher Dr. Anthony Atala, director of the Wake Forest Institute for Regenerative Medicine in North Carolina.
“These results show that the creation of full-thickness, human bioengineered skin is possible, and promotes quicker healing and more naturally appearing outcomes,” Atala said in a Wake Forest news release.
Perfected skin regeneration could provide burn victims, wounded soldiers and those with skin disorders an opportunity for complete healing. The sort of grafts available today have only some of the elements of normal skin, which can lead to a scarred appearance. The creation of full-thickness skin has not been possible to date, the researchers said.
These “printed” skin grafts offer a triple-layer structure for full-thickness wound coverage, the study authors explained.
By subscribing, you consent to receive emails from BlackDoctor.pro You may unsubscribe at any time. Privacy Policy & Terms of Service.
Are you a healthcare professional? Register with us today!